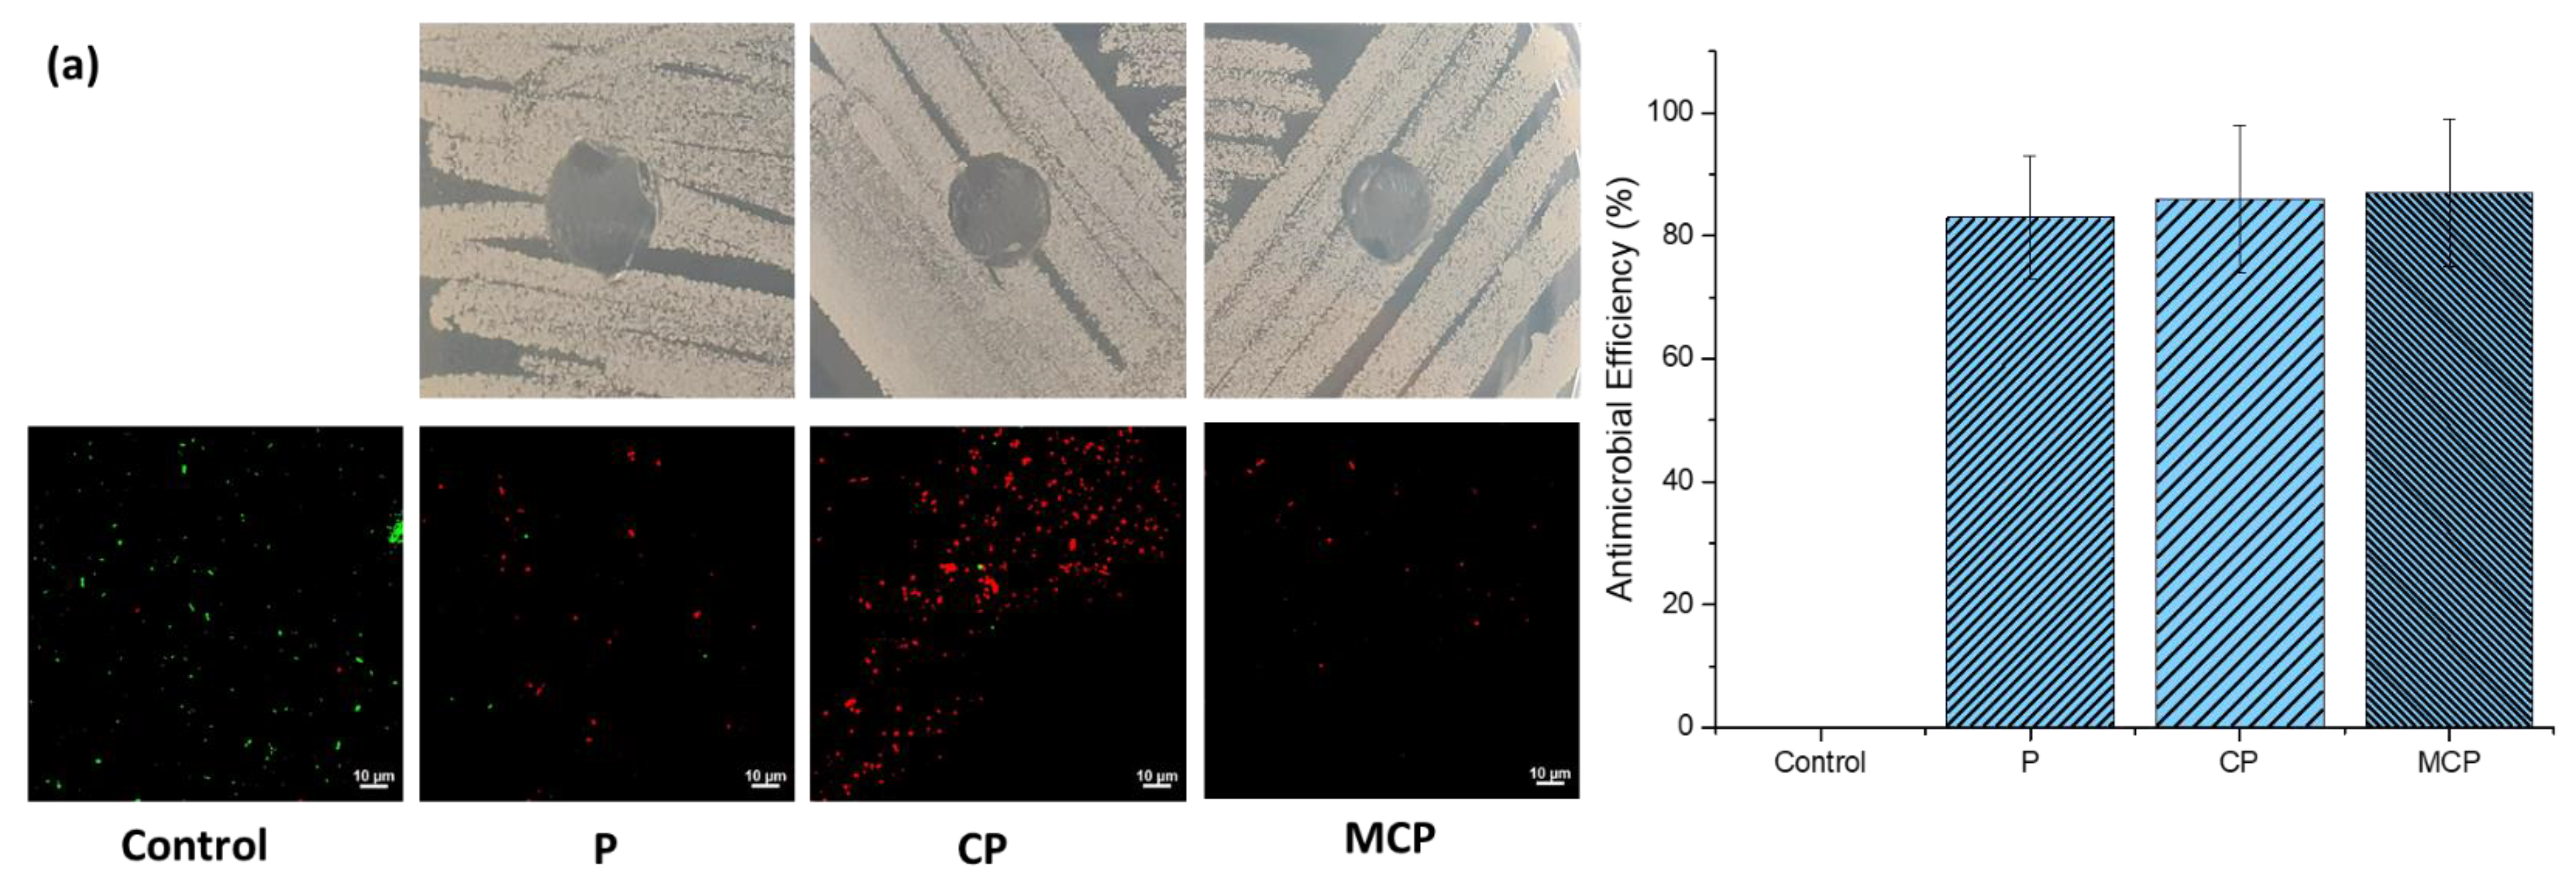

Antifouling and Antimicrobial Study of Nanostructured Mixed-Matrix Membranes for Arsenic Filtration
Abstract
1. Introduction
2. Materials and Methods
2.1. Materials
2.2. Antifouling Study
2.3. Antibacterial Test
3. Results and Discussion
3.1. Antifouling Behaviour of Nanostructured Mixed-Matrix Membranes
3.1.1. Membrane Surface Morphology and Contact Angle
3.1.2. Membrane Fouling Mechanism Study via BET
Fouling of Pristine PSF membrane (P)
Fouling of Mixed-Matrix PSF Membrane with GO–ZnO Composite Particles (CP)
Fouling of Mixed-Matrix PSF Membrane with GO–ZnO–Iron Oxide Composite Particles (MCP)
3.2. Antimicrobial Behaviour of Nanostructured Mixed-Matrix Membranes
4. Conclusions
Author Contributions
Funding
Data Availability Statement
Acknowledgments
Conflicts of Interest
References
- Mastropietro, T.F.; Bruno, R.; Pardo, E.; Armentano, D. Reverse osmosis and nanofiltration membranes for highly efficient PFASs removal: Overview, challenges and future perspectives. Dalton Trans. 2021, 50, 5398–5410. [Google Scholar] [CrossRef] [PubMed]
- Poerio, T.; Piacentini, E.; Mazzei, R. Membrane processes for microplastic removal. Molecules 2019, 24, 4148. [Google Scholar] [CrossRef] [PubMed]
- Qdais, H.A.; Moussa, H. Removal of heavy metals from wastewater by membrane processes: A comparative study. Desalination 2004, 164, 105–110. [Google Scholar] [CrossRef]
- Singh, S.; Sharma, R.; Khanuja, M. A review and recent developments on strategies to improve the photocatalytic elimination of organic dye pollutants by BiOX (X = Cl, Br, I, F) nanostructures. Korean J. Chem. Eng. 2018, 35, 1955–1968. [Google Scholar] [CrossRef]
- Shankar, S.; Shanker, U. Arsenic contamination of groundwater: A review of sources, prevalence, health risks, and strategies for mitigation. Sci. World J. 2014, 2014, 304524. [Google Scholar] [CrossRef] [PubMed]
- Shaji, E.; Santosh, M.; Sarath, K.V.; Prakash, P.; Deepchand, V.; Divya, B.V. Arsenic contamination of groundwater: A global synopsis with focus on the Indian Peninsula. Geosci. Front. 2021, 12, 101079. [Google Scholar] [CrossRef]
- Baker, R.W. Membrane technology. In Kirk-Othmer Encyclopedia of Chemical Technology; John Wiley & Sons: Hoboken, NJ, USA, 2000; Volume 1. [Google Scholar]
- Baker, R.W. Membrane Technology and Applications, 2nd ed.; John Wiley & Sons: Menlo Park, CA, USA, 2012; p. 14. [Google Scholar]
- Yang, Z.; Zhou, Y.; Feng, Z.; Rui, X.; Zhang, T.; Zhang, Z. A review on reverse osmosis and nanofiltration membranes for water purification. Polymers 2019, 11, 1252. [Google Scholar] [CrossRef]
- Pendergast, M.M.; Hoek, E.M. A review of water treatment membrane nanotechnologies. Energy Environ. Sci. 2011, 4, 1946–1971. [Google Scholar] [CrossRef]
- Miller, D.J.; Dreyer, D.R.; Bielawski, C.W.; Paul, D.R.; Freeman, B.D. Surface modification of water purification membranes. Angew. Chem. Int. Ed. 2017, 56, 4662–4711. [Google Scholar] [CrossRef]
- Shirasaki, N.; Matsushita, T.; Matsui, Y.; Ohno, K. Effects of reversible and irreversible membrane fouling on virus removal by a coagulation–microfiltration system. J. Water Supply Res. Technol. AQUA 2008, 57, 501–506. [Google Scholar] [CrossRef]
- Lin, H.; Peng, W.; Zhang, M.; Chen, J.; Hong, H.; Zhang, Y. A review on anaerobic membrane bioreactors: Applications, membrane fouling and future perspectives. Desalination 2013, 314, 169–188. [Google Scholar] [CrossRef]
- Zhao, C.; Xue, J.; Ran, F.; Sun, S. Modification of polyethersulfone membranes–A review of methods. Prog. Mater Sci. 2013, 58, 76–150. [Google Scholar] [CrossRef]
- Kwak, S.-Y.; Kim, S.H.; Kim, S.S. Hybrid organic/inorganic reverse osmosis (RO) membrane for bactericidal anti-fouling. 1. Preparation and characterization of TiO2 nanoparticle self-assembled aromatic polyamide thin-film-composite (TFC) membrane. Environ. Sci. Technol. 2001, 35, 2388–2394. [Google Scholar] [CrossRef]
- Leong, S.; Razmjou, A.; Wang, K.; Hapgood, K.; Zhang, X.; Wang, H. TiO2 based photocatalytic membranes: A review. J. Membr. Sci. 2014, 472, 167–184. [Google Scholar] [CrossRef]
- Bet-Moushoul, E.; Mansourpanah, Y.; Farhadi, K.; Tabatabaei, M. TiO2 nanocomposite based polymeric membranes: A review on performance improvement for various applications in chemical engineering processes. Chem. Eng. J. 2016, 283, 29–46. [Google Scholar] [CrossRef]
- Zhao, S.; Yan, W.; Shi, M.; Wang, Z.; Wang, J.; Wang, S. Improving permeability and antifouling performance of polyethersulfone ultrafiltration membrane by incorporation of ZnO-DMF dispersion containing nano-ZnO and polyvinylpyrrolidone. J. Membr. Sci. 2015, 478, 105–116. [Google Scholar] [CrossRef]
- Sirelkhatim, A.; Mahmud, S.; Seeni, A.; Kaus, N.H.M.; Ann, L.C.; Bakhori, S.K.M.; Hasan, H.; Mohamad, D. Review on Zinc Oxide Nanoparticles: Antibacterial Activity and Toxicity Mechanism. Nanomicro. Lett. 2015, 7, 219–242. [Google Scholar] [CrossRef] [PubMed]
- Balta, S.; Sotto, A.; Luis, P.; Benea, L.; Van der Bruggen, B.; Kim, J. A new outlook on membrane enhancement with nanoparticles: The alternative of ZnO. J. Membr. Sci. 2012, 389, 155–161. [Google Scholar] [CrossRef]
- Bao, Q.; Zhang, D.; Qi, P. Synthesis and characterization of silver nanoparticle and graphene oxide nanosheet composites as a bactericidal agent for water disinfection. J. Colloid. Interface Sci. 2011, 360, 463–470. [Google Scholar] [CrossRef] [PubMed]
- Song, J.J.; Huang, Y.; Nam, S.-W.; Yu, M.; Heo, J.; Her, N.; Flora, J.R.; Yoon, Y. Ultrathin graphene oxide membranes for the removal of humic acid. Sep. Purif. Technol. 2015, 144, 162–167. [Google Scholar] [CrossRef]
- Wang, Z.; Yu, H.; Xia, J.; Zhang, F.; Li, F.; Xia, Y.; Li, Y. Novel GO-blended PVDF ultrafiltration membranes. Desalination 2012, 299, 50–54. [Google Scholar] [CrossRef]
- Chung, Y.T.; Mahmoudi, E.; Mohammad, A.W.; Benamor, A.; Johnson, D.; Hilal, N. Development of polysulfone-nanohybrid membranes using ZnO-GO composite for enhanced antifouling and antibacterial control. Desalination 2017, 402, 123–132. [Google Scholar] [CrossRef]
- Mukherjee, M.; De, S. Reduction of microbial contamination from drinking water using an iron oxide nanoparticle-impregnated ultrafiltration mixed matrix membrane: Preparation, characterization and antimicrobial properties. Environ. Sci. Water Res. Technol. 2015, 1, 204–217. [Google Scholar] [CrossRef]
- Lee, C.; Kim, J.Y.; Lee, W.I.; Nelson, K.L.; Yoon, J.; Sedlak, D.L. Bactericidal Effect of Zero-Valent Iron Nanoparticles on Escherichia coli. Environ. Sci. Technol. 2008, 42, 4927–4933. [Google Scholar] [CrossRef] [PubMed]
- Dallas, P.; Tucek, J.; Jancik, D.; Kolar, M.; Panacek, A.; Zboril, R. Magnetically controllable silver nanocomposite with multifunctional phosphotriazine matrix and high antimicrobial activity. Adv. Funct. Mater. 2010, 20, 2347–2354. [Google Scholar] [CrossRef]
- Prucek, R.; Tuček, J.; Kilianová, M.; Panáček, A.; Kvítek, L.; Filip, J.; Kolář, M.; Tománková, K.; Zbořil, R. The targeted antibacterial and antifungal properties of magnetic nanocomposite of iron oxide and silver nanoparticles. Biomaterials 2011, 32, 4704–4713. [Google Scholar] [CrossRef]
- Siddique, T.; Balu, R.; Mata, J.; Dutta, N.K.; Roy Choudhury, N. Electrospun Composite Nanofiltration Membranes for Arsenic Removal. Polymers 2022, 14, 1980. [Google Scholar] [CrossRef] [PubMed]
- Buysschaert, B.; Byloos, B.; Leys, N.; Van Houdt, R.; Boon, N. Reevaluating multicolor flow cytometry to assess microbial viability. Appl. Microbiol. Biotechnol. 2016, 100, 9037–9051. [Google Scholar] [CrossRef]
- Nabe, A.; Staude, E.; Belfort, G. Surface modification of polysulfone ultrafiltration membranes and fouling by BSA solutions. J. Membr. Sci. 1997, 133, 57–72. [Google Scholar] [CrossRef]
- Zambare, R.S.; Dhopte, K.B.; Nemade, P.R.; Tang, C.Y. Effect of oxidation degree of GO nanosheets on microstructure and performance of polysulfone-GO mixed matrix membranes. Sep. Purif. Technol. 2020, 244, 116865. [Google Scholar] [CrossRef]
- Wu, H.; Tang, B.; Wu, P. Development of novel SiO2–GO nanohybrid/polysulfone membrane with enhanced performance. J. Membr. Sci. 2014, 451, 94–102. [Google Scholar] [CrossRef]
- Shen, L.; Huang, Z.; Liu, Y.; Li, R.; Xu, Y.; Jakaj, G.; Lin, H. Polymeric membranes incorporated with ZnO nanoparticles for membrane fouling mitigation: A brief review. Front. Chem. 2020, 8, 224. [Google Scholar] [CrossRef] [PubMed]
- Said, N.; Hasbullah, H.; Abidin, M.N.Z.; Ismail, A.F.; Goh, P.S.; Othman, M.H.D.; Kadir, S.H.S.A.; Kamal, F.; Abdullah, M.S.; Ng, B.C. Facile modification of polysulfone hollow-fiber membranes via the incorporation of well-dispersed iron oxide nanoparticles for protein purification. J. Appl. Polym. Sci. 2019, 136, 47502. [Google Scholar] [CrossRef]
- Virtanen, T.; Rudolph, G.; Lopatina, A.; Al-Rudainy, B.; Schagerlöf, H.; Puro, L.; Kallioinen, M.; Lipnizki, F. Analysis of membrane fouling by Brunauer-Emmet-Teller nitrogen adsorption/desorption technique. Sci. Rep. 2020, 10, 1–10. [Google Scholar] [CrossRef] [PubMed]
- Mukherjee, M.; De, S. Antibacterial polymeric membranes: A short review. Environ. Sci. Water Res. Technol. 2018, 4, 1078–1104. [Google Scholar] [CrossRef]
- Aryanti, P.; Sianipar, M.; Zunita, M.; Wenten, I. Modified membrane with antibacterial properties. Membr. Water Treat. 2017, 8, 463–481. [Google Scholar]
- Fu, G.; Vary, P.S.; Lin, C.-T. Anatase TiO2 nanocomposites for antimicrobial coatings. J. Phys. Chem. B 2005, 109, 8889–8898. [Google Scholar] [CrossRef]
- Zeng, Z.; Yu, D.; He, Z.; Liu, J.; Xiao, F.-X.; Zhang, Y.; Wang, R.; Bhattacharyya, D.; Tan, T.T.Y. Graphene Oxide Quantum Dots Covalently Functionalized PVDF Membrane with Significantly-Enhanced Bactericidal and Antibiofouling Performances. Sci. Rep. 2016, 6, 20142. [Google Scholar] [CrossRef]
- Kochkodan, V.; Hilal, N.; Goncharuk, V.; Al-Khatib, L.; Levadna, T. Effect of the surface modification of polymer membranes on their microbiological fouling. Colloid J. 2006, 68, 267–273. [Google Scholar] [CrossRef]
- Brayner, R.; Ferrari-Iliou, R.; Brivois, N.; Djediat, S.; Benedetti, M.F.; Fiévet, F. Toxicological impact studies based on Escherichia coli bacteria in ultrafine ZnO nanoparticles colloidal medium. Nano Lett. 2006, 6, 866–870. [Google Scholar] [CrossRef]
- Zhang, L.; Jiang, Y.; Ding, Y.; Povey, M.; York, D. Investigation into the antibacterial behaviour of suspensions of ZnO nanoparticles (ZnO nanofluids). J. Nanopart. Res. 2007, 9, 479–489. [Google Scholar] [CrossRef]
- Adams, L.K.; Lyon, D.Y.; Alvarez, P.J. Comparative eco-toxicity of nanoscale TiO2, SiO2, and ZnO water suspensions. Water Res. 2006, 40, 3527–3532. [Google Scholar] [CrossRef] [PubMed]
- Kasemets, K.; Ivask, A.; Dubourguier, H.-C.; Kahru, A. Toxicity of nanoparticles of ZnO, CuO and TiO2 to yeast Saccharomyces cerevisiae. Toxicol. Vitro 2009, 23, 1116–1122. [Google Scholar] [CrossRef]
- Brunner, T.J.; Wick, P.; Manser, P.; Spohn, P.; Grass, R.N.; Limbach, L.K.; Bruinink, A.; Stark, W.J. In vitro cytotoxicity of oxide nanoparticles: Comparison to asbestos, silica, and the effect of particle solubility. Environ. Sci. Technol. 2006, 40, 4374–4381. [Google Scholar] [CrossRef] [PubMed]
- Li, M.; Zhu, L.; Lin, D. Toxicity of ZnO nanoparticles to Escherichia coli: Mechanism and the influence of medium components. Environ. Sci. Technol. 2011, 45, 1977–1983. [Google Scholar] [CrossRef] [PubMed]
- Sawai, J.; Shoji, S.; Igarashi, H.; Hashimoto, A.; Kokugan, T.; Shimizu, M.; Kojima, H. Hydrogen peroxide as an antibacterial factor in zinc oxide powder slurry. J. Ferment. Bioeng. 1998, 86, 521–522. [Google Scholar] [CrossRef]
- Lipovsky, A.; Nitzan, Y.; Gedanken, A.; Lubart, R. Antifungal activity of ZnO nanoparticles—The role of ROS mediated cell injury. Nanotechnology 2011, 22, 105101. [Google Scholar] [CrossRef]
- Zhang, L.; Ding, Y.; Povey, M.; York, D. ZnO nanofluids–A potential antibacterial agent. Prog. Nat. Sci. 2008, 18, 939–944. [Google Scholar] [CrossRef]
- Jalal, R.; Goharshadi, E.K.; Abareshi, M.; Moosavi, M.; Yousefi, A.; Nancarrow, P. ZnO nanofluids: Green synthesis, characterization, and antibacterial activity. Mater. Chem. Phys. 2010, 121, 198–201. [Google Scholar] [CrossRef]
- Al-Hinai, M.H.; Sathe, P.; Al-Abri, M.Z.; Dobretsov, S.; Al-Hinai, A.T.; Dutta, J. Antimicrobial Activity Enhancement of Poly(ether sulfone) Membranes by in Situ Growth of ZnO Nanorods. ACS Omega 2017, 2, 3157–3167. [Google Scholar] [CrossRef]
- Javdaneh, S.; Mehrnia, M.R.; Homayoonfal, M. Engineering design of a biofilm formed on a pH-sensitive ZnO/PSf nanocomposite membrane with antibacterial properties. RSC Adv. 2016, 6, 112269–112281. [Google Scholar] [CrossRef]
- Stanicki, D.; Boutry, S.; Laurent, S.; Wacheul, L.; Nicolas, E.; Crombez, D.; Vander Elst, L.; Lafontaine, D.L.J.; Muller, R.N. Carboxy-silane coated iron oxide nanoparticles: A convenient platform for cellular and small animal imaging. J. Mater. Chem. B 2014, 2, 387–397. [Google Scholar] [CrossRef] [PubMed]
- El-Shafai, N.; El-Khouly, M.E.; El-Kemary, M.; Ramadan, M.; Eldesoukey, I.; Masoud, M. Graphene oxide decorated with zinc oxide nanoflower, silver and titanium dioxide nanoparticles: Fabrication, characterization, DNA interaction, and antibacterial activity. RSC Adv. 2019, 9, 3704–3714. [Google Scholar] [CrossRef]
- Archana, S.; Kumar, K.Y.; Jayanna, B.; Olivera, S.; Anand, A.; Prashanth, M.; Muralidhara, H. Versatile graphene oxide decorated by star shaped zinc oxide nanocomposites with superior adsorption capacity and antimicrobial activity. J. Sci. Adv. Mater. Dev. 2018, 3, 167–174. [Google Scholar] [CrossRef]

| Membranes | Contact Angle (°) | BET Surface Area (m2/g) | Pore Surface Area (m2/g) | Pore Volume (cm3/g) | Desorption Pore Size (nm) | Micropore Area (m2/g) | Micropore Volume (cm3/g) | |
|---|---|---|---|---|---|---|---|---|
| P | Before Fouling | 125 ± 2 | 55.1 | 82.53 | 0.35 | 16.75 | * | * |
| BSA-Fouled Membrane | - | 61.36 | 29.82 | 0.11 | 14.7 | 1.39 | 0.0003 | |
| CP | Before Fouling | 104 ± 3 | 19.96 | 62.3 | 0.33 | 17.5 | * | * |
| BSA-Fouled Membrane | 56 ± 3 | 40.89 | 38.13 | 0.22 | 15.72 | 0.19 | * | |
| MCP | Before Fouling | 87 ± 5 | 18.97 | 76.07 | 0.31 | 25.11 | * | * |
| BSA-Fouled Membrane | - | 38.37 | 35.61 | 0.16 | 13.7 | * | * | |
Disclaimer/Publisher’s Note: The statements, opinions and data contained in all publications are solely those of the individual author(s) and contributor(s) and not of MDPI and/or the editor(s). MDPI and/or the editor(s) disclaim responsibility for any injury to people or property resulting from any ideas, methods, instructions or products referred to in the content. |
© 2023 by the authors. Licensee MDPI, Basel, Switzerland. This article is an open access article distributed under the terms and conditions of the Creative Commons Attribution (CC BY) license (https://creativecommons.org/licenses/by/4.0/).
Share and Cite
Siddique, T.; Gangadoo, S.; Quang Pham, D.; Dutta, N.K.; Choudhury, N.R. Antifouling and Antimicrobial Study of Nanostructured Mixed-Matrix Membranes for Arsenic Filtration. Nanomaterials 2023, 13, 738. https://doi.org/10.3390/nano13040738
Siddique T, Gangadoo S, Quang Pham D, Dutta NK, Choudhury NR. Antifouling and Antimicrobial Study of Nanostructured Mixed-Matrix Membranes for Arsenic Filtration. Nanomaterials. 2023; 13(4):738. https://doi.org/10.3390/nano13040738
Chicago/Turabian StyleSiddique, Tawsif, Sheeana Gangadoo, Duy Quang Pham, Naba K. Dutta, and Namita Roy Choudhury. 2023. "Antifouling and Antimicrobial Study of Nanostructured Mixed-Matrix Membranes for Arsenic Filtration" Nanomaterials 13, no. 4: 738. https://doi.org/10.3390/nano13040738
APA StyleSiddique, T., Gangadoo, S., Quang Pham, D., Dutta, N. K., & Choudhury, N. R. (2023). Antifouling and Antimicrobial Study of Nanostructured Mixed-Matrix Membranes for Arsenic Filtration. Nanomaterials, 13(4), 738. https://doi.org/10.3390/nano13040738

